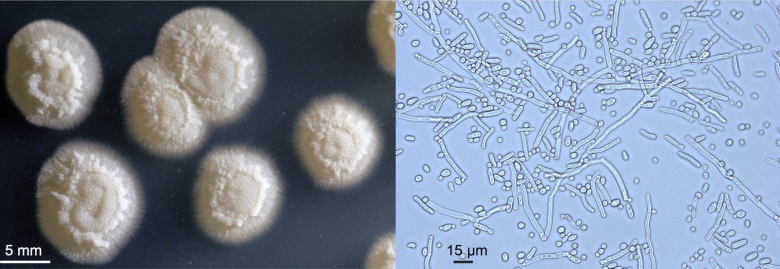
Оидиум Лактис под микроскопом

Клеточный гриб (53 фото)

Строение клеток грибов дрожжей

Схема строения клетки гриба

Строение клеточной стенки гриба

Гриб решеточник красный

Гриб решеточник красный

Мукормикоз черная плесень

Грибковая клетка

Penicillium notatum пенициллин

Красный решеточник

Прокариотические и эукариотические клетки

Строчок обыкновенный гриб

Структура клеточной стенки гриба

Дрожжей Saccharomyces cerevisiae микроскопия

Клетки лишайника под микроскопом

Лерациомицес гриб

Размножение шляпочного гриба схема

Лерациомицес

Дрожалка оранжевая гриб

Гриб Stemonitis Fusca

Грибы вызывающие болезни растений под микроскопом

Паутинник благородный

Многоядерная клетка гриба

Гриб под микроскопом

Animal cell

Дрожжи Saccharomyces cerevisiae

Препарат плесень мукор

Строение клеток растений животных грибов и бактерий

Решёточник красный гриб
Оидиум Лактис под микроскопом

Грибы Брянской области

Ежовик кровоточащий гриб

Плесневые грибы аспергиллус

Строение клеточной стенки гриба

Строение дрожжевой клетки

Строение слоевища лишайника

Дрожжи Saccharomyces cerevisiae

Плесневые грибы аспергилл

Грибы маслята в Ленинградской области

Плесневые грибы пенициллиум

Гриб Russula cyanoxantha

Гриб с жидкостью внутри

Строение грибной клетки дрожжи

Микроскопия паразитарные грибы

Сапролегния мицелий

Грибочек из Марио пиксельный

Родотус дланевидный

Panus fasciatus гриб

Строение эукариотной грибной клетки

Гриб решеточник красный

Плесневые грибы пенициллиум

Лисичка гриб картинка для детей

Текстура шляпки гриба

Клетки мицелия гриба под микроскопом

Схема строения грибной клетки

Решеточник решеточник красный

Ядовитый гриб решеточник красный

Гриб решеточник красный

Решеточник красный гриб

Грибы грифола курчавая решёточник красный паутинник фиолетовый

Решёточник красный

Гриб решеточник красный

Решеточник красный красная книга

Гриб решеточник красный

Ядовитый гриб решеточник красный

Решеточник красный кавказский заповедник

Гриб решеточник красный

Гриб решеточник красный

Красный решеточник

Красный клатрус гриб

Красный клатрус гриб

Решёточник красный

Ядовитый гриб решеточник красный

Решёточник красный гриб

Гриб решеточник красный

Решеточник красный красная книга

Гриб решеточник

Решеточник красный гриб

Гриб решеточник

Красный решеточник

Ядовитый гриб решеточник

Гриб решеточник красный

Гриб решеточник красный

Решеточник красный гриб
Поделиться фото в социальных сетях:
Комментариев (0)
Похожие фото:











